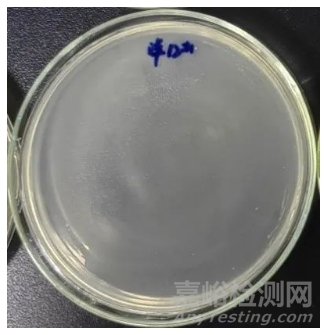

您當(dāng)前的位置:檢測(cè)資訊 > 科研開(kāi)發(fā)
嘉峪檢測(cè)網(wǎng) 2025-04-27 13:03
1.初步認(rèn)識(shí)洋蔥伯克霍爾德菌
洋蔥伯克霍爾德菌(Burkholderia cepacia,簡(jiǎn)稱B.c,下同) 屬于革蘭陰性桿菌,直徑約為0.8~1.0μm,長(zhǎng)度約為1.6~3.2μm,具有多根極端鞭毛,需氧非發(fā)酵菌,是植物病原菌。
1950年,康奈爾大學(xué)教授Burkholder首次在腐爛的洋蔥根莖中分離,分離之初被命名為洋蔥假單胞菌(Pseudomonas cepacia)。1992年,Yabuuchi等通過(guò)多相分類學(xué),依據(jù)16S rRNA序列、DNA-DNA雜交同源性、表征特征和脂肪酸組成等,該菌被重新分類命名為洋蔥伯克霍爾德菌。

圖1 掃描電子顯微鏡下的洋蔥伯克霍爾德菌
隨著分子生物學(xué)的飛速發(fā)展,1997年,Vandamme等通過(guò)生化分析表明128株B.c被鑒定為若干菌株,被劃分為至少5個(gè)不同的基因型。同年5月召開(kāi)的B.c國(guó)際工作組會(huì)議上,提議將上述表型特征近似的基因型亞群命名為洋蔥伯克霍爾德菌群(Burkholderia cepacia complex,簡(jiǎn)稱Bcc,下同) ,隸屬于伯克霍爾德菌屬(Burkholderia)。
截止至2021年,已被分類命名的Bcc成員達(dá)到了24種 ,具體見(jiàn)圖2-1、圖2-2所示。


圖2-1 洋蔥伯克霍爾德菌群已分類命名種
Bcc菌種歸屬:細(xì)菌界→變形菌門→β-變形菌綱→伯克氏菌目→伯克氏菌科→伯克氏菌屬→洋蔥伯克霍爾德群(代表菌種為B.c)。

圖2-2 洋蔥伯克霍爾德菌群已分類命名種
那洋蔥伯克霍爾德菌群(Bcc)和洋蔥伯克霍爾德菌(B.c)到底是什么關(guān)系呢?這個(gè)分類又該如何理解呢?
我們可以用很常見(jiàn)的歌曲專輯來(lái)打個(gè)比方:一張專輯下包括許多首歌曲,往往這些歌曲中,至少會(huì)有一首主打歌,主打歌的旋律總會(huì)讓我們不經(jīng)意間就會(huì)哼唱起來(lái)。B.c就是Bcc的“主打歌”,只不過(guò)是“主打歌”和“專輯”幾乎同名了而已。B.c也是實(shí)驗(yàn)室經(jīng)常會(huì)用到的菌種。
從ATCC官網(wǎng)上可以查到,目前在售的一共有四種B.c,不同的菌種號(hào)代表不同的提取來(lái)源,如圖3所示。其中ATCC 25416被標(biāo)記為標(biāo)準(zhǔn)菌株,提取于洋蔥中。該菌也是目前化妝品試驗(yàn)以及我司實(shí)驗(yàn)室的常用菌株。

圖3 ATCC在售B.c菌種(來(lái)自ATCC官網(wǎng))
CTFA的日化產(chǎn)品防腐效能評(píng)價(jià)測(cè)試方法中,把菌號(hào)為ATCC 25416的洋蔥伯克霍爾德菌作為革蘭氏陰性桿菌(不產(chǎn)氣)中的可選菌株,如圖4所示,可根據(jù)需求選取該菌對(duì)相應(yīng)產(chǎn)品進(jìn)行防腐挑戰(zhàn)測(cè)試。

圖4 CTFA Microbiology Guidelines 2007試驗(yàn)菌株
2.洋蔥伯克霍爾德菌群多樣化的生存環(huán)境
眾多文獻(xiàn)表明,Bcc在自然界中是很常見(jiàn)的,廣泛分布于土壤、水、植物的根周外等等。比如:
《非無(wú)菌藥品中不可接受微生物的控制與風(fēng)險(xiǎn)評(píng)估》中寫(xiě)到洋蔥伯克霍爾德菌廣泛存在于自然界如土壤、水、植物根際和農(nóng)產(chǎn)品中。該菌能夠在寡營(yíng)養(yǎng)的條件下如純水中存活,甚至在12℃或48℃條件下仍然能夠生長(zhǎng)繁殖。在管道中常常形成生物膜,并且無(wú)規(guī)律地從管道內(nèi)壁脫落,導(dǎo)致微生物檢測(cè)中出現(xiàn)不均勻污染現(xiàn)象;
《<中國(guó)藥典>擬收載洋蔥伯克霍爾德菌群(Bcc)檢查法中標(biāo)準(zhǔn)菌株的穩(wěn)定性研究》中寫(xiě)到Bcc生存能力強(qiáng),在土壤、水和植物根際等自然環(huán)境中廣泛存在,對(duì)營(yíng)養(yǎng)需求較低,能在蒸餾水中存活數(shù)月,容易在制藥用水中駐留并形成生物膜,最終引入產(chǎn)品;
《化妝品生產(chǎn)中抗性環(huán)境菌株的研究》中寫(xiě)到伯克霍爾德菌屬可以在營(yíng)養(yǎng)極低的環(huán)境中生長(zhǎng),廣泛存在于土壤和水中;
《一株樣品分離菌-洋蔥伯克霍爾德菌對(duì)抑菌效力評(píng)價(jià)體系的啟示》中寫(xiě)到洋蔥伯克霍爾德菌是一種廣泛存在于水、土壤、植物和人體中的革蘭氏陰性菌;
《飲水中洋蔥伯克霍爾德菌的分離鑒定及消毒劑滅活試驗(yàn)》中寫(xiě)到洋蔥伯克霍爾德菌廣泛存在于水、土壤、植物和人體中,是一種機(jī)會(huì)致病菌等等。
更有文獻(xiàn)表明,Bcc對(duì)部分抗生素、消毒劑和抑菌劑具有天然抗性。比如:
《中國(guó)衛(wèi)生檢驗(yàn)雜志》收錄的文獻(xiàn)中寫(xiě)到在罐裝24h后的礦泉水中檢出洋蔥假單胞菌;
《Journal of Infection》收錄的文獻(xiàn)中寫(xiě)到一株洋蔥假單胞菌在0.05%苯扎氯銨作為抗菌劑的無(wú)機(jī)鹽溶液中作為污染物存活了14年(1963~1977年);
《預(yù)防醫(yī)學(xué)文獻(xiàn)信息》收錄的文獻(xiàn)中寫(xiě)到在洗發(fā)膏中檢出洋蔥假單胞菌;
《抗感染藥學(xué)》收錄的文獻(xiàn)種寫(xiě)到在含有尼泊金酯的抗真菌乳膏中檢出洋蔥伯克霍爾德菌群;
《中國(guó)衛(wèi)生檢驗(yàn)雜志》收錄的文獻(xiàn)中寫(xiě)到在0.1%洗必泰消毒劑中檢出一株洋蔥假單胞菌等等。
可見(jiàn)Bcc強(qiáng)大的代謝能力支持它適應(yīng)不同的環(huán)境,由該菌引起的污染事件時(shí)有發(fā)生。目前該菌已經(jīng)被FDA明確為不可接受微生物(objectionable microorganism),我國(guó)藥品評(píng)審中心在2021年發(fā)布的“化學(xué)藥品創(chuàng)新藥上市申請(qǐng)前會(huì)議藥學(xué)共性問(wèn)題及相關(guān)技術(shù)要求”中明確規(guī)定水基質(zhì)非無(wú)菌制劑應(yīng)開(kāi)展洋蔥伯克霍爾德菌研究,并制定相應(yīng)的控制策略,中國(guó)食品藥品檢定研究院承擔(dān)了“洋蔥伯克霍爾德菌群檢查法的建立”課題,如圖8、9所示。

圖8 我國(guó)藥品評(píng)審中心在2021年發(fā)布的“化學(xué)藥品創(chuàng)新藥上市申請(qǐng)前會(huì)議藥學(xué)共性問(wèn)題及相關(guān)技術(shù)要求”
3.洋蔥伯克霍爾德菌群的危害
Bcc是一種條件致病菌(比如大腸桿菌就是很常見(jiàn)的條件致病菌,正常情況下大腸桿菌是人和動(dòng)物腸道中的常居菌,屬于互利共生關(guān)系,但在一定條件下,比如免疫力下降、菌群失調(diào)等也會(huì)引發(fā)一些疾?。?,對(duì)健康群體通常不致病,主要在免疫功能低下的人群中引起疾病??梢远ㄖ秤诨颊吆粑?,導(dǎo)致囊性纖維化患者或免疫力低下患者不同程度的肺部感染。
1980年,美國(guó)某吸入劑生產(chǎn)企業(yè)由于去離子水制備系統(tǒng)控制失敗,致使產(chǎn)品污染洋蔥伯克霍爾德菌,導(dǎo)致數(shù)名囊性纖維化(Cysticfibrosis,CF)患者死亡。也因此事件,F(xiàn)DA(Food and Drug Administration)開(kāi)始關(guān)注該菌。
近年來(lái),不斷有因?yàn)樗幤泛托l(wèi)生用品在內(nèi)的健康產(chǎn)品污染Bcc而召回的案例,F(xiàn)DA也因該菌的疑似污染,發(fā)布若干次警告信息。
2017年,F(xiàn)DA發(fā)布關(guān)于建議水基質(zhì)的非無(wú)菌藥品制造商應(yīng)關(guān)注由Bcc造成的微生物污染風(fēng)險(xiǎn)。
2019年5月15日,Skyn Iceland 卸妝水在全國(guó)范圍內(nèi)自愿召回,召回原因?yàn)楫a(chǎn)品中檢出洋蔥伯克霍爾德菌。
2021年1月17日,Scent Theory Products Llc 泡沫洗手液在全國(guó)范圍內(nèi)自愿召回,召回原因?yàn)楫a(chǎn)品可能被洋蔥伯克霍爾德菌污染。
2022年4月13日,PM Concepts LLC爽膚水在全國(guó)范圍內(nèi)自愿召回,召回原因?yàn)楫a(chǎn)品被洋蔥伯克霍爾德菌污染。
我們統(tǒng)計(jì)了從2018年至今FDA關(guān)于化妝品的召回信息。在118種召回化妝品中,有73種化妝品因?yàn)槲⑸镂廴颈徽倩?。其中又?1種與洋蔥伯克霍爾德菌污染有關(guān),約占因微生物污染召回事件的42%。召回的產(chǎn)品包括化妝水、卸妝水、漱口水、洗發(fā)液、洗手液等。如圖10、11所示。

圖10 2018年至今FDA關(guān)于化妝品的召回信息統(tǒng)計(jì)

圖11 化妝品召回信息(來(lái)自FDA官網(wǎng))
因此Bcc的預(yù)防及防控對(duì)濕巾及化妝品廠家至關(guān)重要。
4.如何鑒別洋蔥伯克霍爾德菌群
不同鑒定方法能達(dá)到的鑒定水平是有差異的, Bcc可參考的標(biāo)準(zhǔn)方法,包括《SN/T 4684-2016 進(jìn)出口化妝品中洋蔥伯克霍爾德菌檢驗(yàn)方法》、《SN/T 4485-2016 進(jìn)出口口腔清潔類產(chǎn)品中洋蔥伯克霍爾德菌檢驗(yàn)方法》、《USP <60>非無(wú)菌產(chǎn)品的洋蔥伯克霍爾德菌群檢查》,這三種方法均為選擇性培養(yǎng),適用于菌種的初步鑒定。如果要具體甄別到屬于Bcc的24個(gè)菌種中的哪一個(gè),比如確定污染菌是否為B.c(洋蔥伯克霍爾德菌),這需要進(jìn)行深一步的基因序列鑒定及分析。
由于不同行業(yè)對(duì)于鑒定的應(yīng)用需求是不同的,目前這三種檢測(cè)方法可以滿足化妝品或者濕巾行業(yè)的基本需求,也是目前最為常用的方法。具體檢測(cè)流程見(jiàn)圖5所示。Bcc可能存在的指示特征是在 BCSA 上生長(zhǎng)帶黃色光暈的綠棕色菌落或被粉紅色區(qū)域包圍的白色菌落。

圖5. 各標(biāo)準(zhǔn)進(jìn)行Bcc檢驗(yàn)的流程
5.工廠如何防控洋蔥伯克霍爾德菌群
對(duì)于Bcc的防控,我們先看看Bcc的生長(zhǎng)習(xí)性。
1)工廠消殺管理制度及流程設(shè)計(jì)有無(wú)缺陷環(huán)節(jié);
2)人員、機(jī)器、原料、環(huán)境等清潔及消毒是否存在不到位,管理是否有欠缺(比如:設(shè)備干燥時(shí)間不夠、中間料體儲(chǔ)存不當(dāng)、最終產(chǎn)品滅菌不充分);
3)水系統(tǒng)設(shè)計(jì)(比如:死水中更容易產(chǎn)生生物膜);
4)生產(chǎn)用水控制如何,是否定期維護(hù),是否能達(dá)到凈化要求等級(jí);
5)對(duì)關(guān)鍵產(chǎn)品表面和設(shè)備處理程序的驗(yàn)證或環(huán)境監(jiān)測(cè)是否合理;
6)微生物測(cè)試及分析是否及時(shí)、全面。
其中最重要的環(huán)節(jié)是對(duì)生產(chǎn)用水的微生物質(zhì)量控制。
除了上述Bcc防控措施,在進(jìn)行工廠消殺時(shí),有沒(méi)有抗抑菌劑數(shù)據(jù)可以參考?
研發(fā)產(chǎn)品配方時(shí),選用什么體系更好的預(yù)防和保護(hù)產(chǎn)品呢?
6.哪些抗抑菌劑對(duì)洋蔥伯克霍爾德菌群有作用
我們從文獻(xiàn)中也見(jiàn)到過(guò)消毒劑及不同溫度熱水對(duì)Bcc的殺滅作用。比如暴露于0.5%潔爾滅15s內(nèi)、0.1%烷基二氨基乙基甘氨酸1min內(nèi),菌懸液中Bcc生存率降到0.001%或更低;暴露于0.1%潔爾滅或0.5%葡萄糖酸洗必泰60min后,存活率降到原來(lái)的0.1%;暴露于65℃及以上熱水中15s后,菌懸液中的Bcc即可被殺滅。
除上述文獻(xiàn)數(shù)據(jù),我公司微生物實(shí)驗(yàn)室利用自身優(yōu)勢(shì),持續(xù)對(duì)該菌進(jìn)行關(guān)注。下面分別以化妝品相關(guān)的微生物試驗(yàn)以及我司實(shí)驗(yàn)室的常用菌株B.c(即ATCC 25416)以及受洋蔥菌污染的產(chǎn)品為例,通過(guò)抑菌環(huán)試驗(yàn),評(píng)估不同的抑、殺菌劑對(duì)B.c的功效,從而更好地指導(dǎo)工廠進(jìn)行防控。

備注:
1、抑菌環(huán)試驗(yàn)是利用抑菌劑不斷溶解經(jīng)瓊脂擴(kuò)散形成不同濃度梯度,以顯示其抑菌作用。抑菌環(huán)大于7mm,則有抑菌作用。
2、參考方法:《消毒技術(shù)規(guī)范》(2002年版)2.1.8.2抑菌環(huán)試驗(yàn)
3、產(chǎn)品污染菌*指從客戶受污染產(chǎn)品中分離出的菌群(經(jīng)菌種鑒定,包括洋蔥伯克霍爾德菌、伯克霍爾德菌屬等)
從以上抑菌環(huán)數(shù)據(jù)中可以看出,目前常見(jiàn)的抗、抑菌劑對(duì)B.c都是有抑制作用的,其中桑普® BC(芐索氯銨)、桑普® LPC(月桂基吡啶氮鎓氯化物)、桑普® CHD-G(葡萄糖氯己定)的效果都很不錯(cuò)。在濕巾配方研發(fā)中,可以選擇加入這些殺菌劑,增強(qiáng)產(chǎn)品對(duì)B.c的防控作用。
像過(guò)氧化氫、酒精這類常用于環(huán)境消殺的產(chǎn)品,對(duì)B.c的抑制作用也很明顯,在抑菌環(huán)試驗(yàn)中75%酒精的平皿甚至已接近透明,如圖6所示(實(shí)驗(yàn)室數(shù)據(jù))。所以在工廠日常消殺工作中,可以選擇這類產(chǎn)品進(jìn)行消殺工作。
圖6. 使用75%酒精進(jìn)行抑菌環(huán)試驗(yàn)的平皿
但從受洋蔥菌污染的產(chǎn)品情況與單純B.c結(jié)果來(lái)看,數(shù)據(jù)相差甚大。這是為什么呢?
其實(shí)我們?cè)谏掀趦?nèi)容中提到已被分類命名的Bcc成員達(dá)到了24種(見(jiàn)上期圖2、3),在進(jìn)行產(chǎn)品污染菌鑒定中,極少或者不可能出現(xiàn)單一的、純化的菌種污染。但目前化妝品試驗(yàn)以及我司實(shí)驗(yàn)室的常用菌株選取的其中一種,即ATCC 25416,它被ATCC標(biāo)記為標(biāo)準(zhǔn)菌株。并且鑒于菌種不斷擴(kuò)大及鑒定能力等原因,并不是每種Bcc成員都可以被精準(zhǔn)無(wú)誤的確定命名。
與其糾結(jié)到底哪種防腐殺菌劑對(duì)Bcc有作用,不如做好工廠的微生物防控,包括人員、機(jī)器設(shè)備、原料(尤其是水)、環(huán)境、管理制度等等,從源頭把關(guān),控制好每個(gè)環(huán)節(jié)和流程,最大限度地減少微生物污染事件發(fā)生!
7.寫(xiě)在最后
Bcc這么可怕嗎?那我們豈不是很容易就被感染了?
放心吧!一般健康人并不是Bcc的菜,接觸到了也不一定會(huì)感染。就像上期談到的,Bcc是一種條件致病菌(比如大腸桿菌就是很常見(jiàn)的條件致病菌,正常情況下大腸桿菌是人和動(dòng)物腸道中的常居菌,屬于互利共生關(guān)系。但在一定條件下,比如免疫力下降、菌群失調(diào)等才會(huì)引發(fā)一些疾?。饕诿庖吖δ艿拖碌娜巳褐幸鸺膊?。易感染的特定人群包括老年人、幼兒、癌癥患者、孕婦和慢性病患者。Bcc很少引起健康人的呼吸道感染,這是因?yàn)榻】等说臍獾鲤つだw毛功能是正常的,可以將Bcc從呼吸道中排除。

來(lái)源:Internet